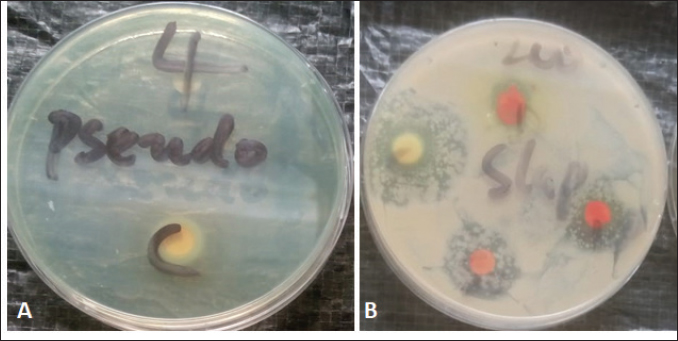

| Research Article | ||
J Microbiol Infect Dis. 2024; 14(3): 120-130 J. Microbiol. Infect. Dis., (2024), Vol. 14(3): 120–130 Original Research Antimicrobial properties of flavonoids and saponins of ginger (Zingiber officinale L) and garlic (Allium sativum) on Staphylococcus aureus and Pseudomonas aeruginosaVictor Kasi Robinson1*, Prince Nornubari Barika1, Solomon Ikechi Ogbonna1 and Anita Nengi-Benwari21Department of Microbiology, Rivers State University, Port Harcourt, Nigeria 2Department of Crop and Soil Science, University of Port Harcourt, Port Harcourt, Nigeria *Corresponding Author: Cajethan Onyebuchi Ezeamagu. Department of Microbiology, Babcock University, Ilishan, Nigeria. Email: onyezecajeth [at] yahoo.com Submitted: 16/08/2024 Accepted: 08/09/2024, Published: 30/09/2024 © 2024 Journal of Microbiology and Infectious Diseases
ABSTRACTBackground: Bioactive components of plants are significant plant metabolites that are known to possess antimicrobial properties. Aim: The antimicrobial properties of flavonoids and saponins of ginger (Zingiber officinale) and garlic (Allium sativum) on Pseudomonas aeruginosa and Staphylococcus aureus were investigated. Methods: The isolates of P. aeruginosa and S. aureus were obtained from the Microbiology Laboratory, Department of Microbiology, Rivers State University, and their identities were confirmed by subjecting them to standard biochemical procedures. The extraction of crude extracts of saponins and flavonoids was carried out using a standard method. The extracts were prepared into different concentrations and impregnated on sterile discs for antimicrobial susceptibility testing. Results: The mean range of flavonoids in ginger was 211.74 ± 1.16–341.74 ± 1.16 g while the range in garlic was 206.11 ± 0.63–399.65 ± 0.63 g. Saponins in ginger ranged from 2.5 ± 0.01 to 3.10% ± 0.01 % while in garlic, it ranged from 8.5 ± 0.02 to 12.77% ± 0.02%. The zone of inhibition of the saponin extract of ginger on P. aeruginosa ranged from 0.0 ± 0.0 to 11.5 ± 0.7 mm, while the range on S. aureus was 0.0 ± 0.0–18.0 ± 0.0 mm. The zone of inhibition of the flavonoid extract of the ginger on S. aureus was 0.0 ± 0.0–13.0 ± 1.4 mm, while the range on P. aeruginosa was 0.0 ± 0.0–12.0 ± 0.0 mm. The zone inhibition of the saponin extract of garlic on S. aureus ranged from 0.0 ± 0.0 to 13 ± 0.0 mm, while for P. aeruginosa it ranged from 0.0 ± 0.0 to 12.0 ± 1.4 mm. The zone of inhibition of the flavonoid extract of garlic on S. aureus ranged from 0.0 ± 0.0 to 14.5 ± 0.7 mm while on P. aeruginosa, it ranged from 0.0 ± 0.0 to 18.5 ± 0.7 mm. The antibacterial effect of the extract was influenced by the concentration. Conclusion: The flavonoid extracts of ginger and garlic displayed better antibacterial activity on P. aeruginosa while the saponin extract was best on S. aureus. Keywords: Antimicrobial activity, Ginger, Garlic, P. aeruginosa, S. aureus. IntroductionThe development and use of traditional herbal medicine have a historical background that dates back to the Stone Age. On the continent of Africa, the practice of traditional healing and magic is much older than some of the other traditional medical sciences (Chavunduka, 2017) and seems to be much more prevalent compared to conventional medicine. African traditional medicine is a form of holistic health care system that is organized into three levels of speciality, which include divination, spiritualism, and herbalism, though these may overlap in some situations (Mahomoodally 2013; Chavunduka 2017). Phytochemicals are regarded as naturally occurring chemical compounds in plants and phytochemicals not limited to flavonoids, saponins, alkaloids, and phytosterols are beneficial in boosting immune responses, against diseases and used as therapeutics for varying diseases (Khalid et al., 2018). Muhammad et al., (2014) documented that plant bioactive components are known for different biological and chemical activities ranging from antimicrobial activity (alkaloids) and antioxidant activity (flavonoids and phenols) to anti-inflammatory, antioxidant, anticancer, insecticidal, and antimicrobial activity (saponins). In previous studies, it was reported that the presence of a high number of phytochemical (bioactive) components (tannins, saponins, flavonoids, phenols, and so on) in plant extracts is primarily responsible for their antibacterial and anti-biofilm actions (Yin et al., 2015; Husain et al., 2015; Kali et al., 2016; Romero et al., 2016; Akani and Barika, 2018). The antibacterial and anti-biofilm actions of these extracts varied due to variances in their chemical contents and the volatile nature of their components (Mostafa et al., 2018). Ginger (Zingiber officinale) and garlic (Allium sativum) are food spice and are known to possess antibacterial activity. The phenolic compounds are the most active ingredients in ginger and they function by disrupting the membrane of microorganisms thereby inhibiting the multiplication of the organisms (Rahman et al., 2020). Garlics on the other hand contain allicin as one of the major bioactive components and the spice has been reported to display broad-spectrum antimicrobial activities against Gram-positive and negative bacterial isolates (Magryś et al., 2021). Due to the wide spread of resistant bacteria especially Staphylococcus aureus and Pseudomonas aeruginosa, the need for alternative approaches geared towards the control or treatment of diseases associated with these bacteria has risen. This study therefore investigated the antimicrobial properties of flavonoid and saponins of ginger and garlic on S. aureus and P. aeruginosa from clinical samples. Materials and MethodsIsolation, identification and preservation of S. aureus and P. aeruginosaPure cultures of S. aureus (10) and P. aeruginosa (10) isolated from clinical specimens (urine, wound, ear swab, and stool) were obtained from the Department of Microbiology Laboratory, Faculty of Science, Rivers State University and their identities were confirmed by subjecting the isolates to biochemical tests such as catalase, oxidase, citrate, sugar fermentation, Voges Proskauer, and methyl red. The isolates were preserved in 10% glycerol and were subcultured for further use. Collection of plantsGinger (Z. officinale) and garlic (A. sativum) were bought randomly from vendors in the Mile III market. The spices were collected in clean polyethylene bags and were transported to the microbiology laboratory, Department of Microbiology, Faculty of Science, Rivers State University, Nigeria. The spices were identified by Professor E. C. Chuku of the Plant Science and Biotechnology Department as ginger (Z. officinale) and garlic (A. sativum). Phytochemical analysis of extractThe extracts were screened quantitatively for the presence of flavonoids and saponins (Kibiti and Afolayan, 2015; Gul et al., 2017). Preparation of crude extracts of ginger and garlic The ginger and garlic were prepared as described by Kibiti and Afolayan (2015). In this method, these spices were rinsed with sterile distilled water, air dried, and ground to homogenous powder using a sterile blender (sterilized with 96% ethanol). Extraction of flavonoids from spices (ginger and garlic)Arora and Itankar’s (2018) method was applied to separate the flavonoids from the ginger and garlic spices. Flash column chromatography was performed on spherical silica gel, C-18; 40–63 microns (230–400 mesh), 60 pore size, and a pH range of 6.5–7.5 in glass columns designed especially for FCC. Glass flash columns were manually dry-packed with C-18 silica. After the column was packed and the apparatus was attached, a volume of the initial solvent mixture was forced through the silica to eliminate air and moisten and equilibrate the column. In a solid sample loading cartridge, Teflon discs were positioned between the samples (extracts or fractions), which had been dried and triturated three times using column silica. The top of the column was covered with a cartridge that was loaded with samples before elution. Fractions were collected in test tubes that had graduated markings on the fraction volume and number. The different compounds were separated using the following flash chromatographic parameters: The equilibration volume was 100 ml, the run length was 270 minutes, the flow rate was 21 ml/minute, and the peak detection method was slope-based. Extraction of saponins from ginger and garlic spicesThe Shah et al. (2014) method was used to separate the saponins from the spices. To extract the crude saponins (CS), the 20 g powdered sample was heated for 4 hours at 55°C with 100 ml of 20% ethanol. 200 ml of 20% ethanol were used to extract the residue once more following the extract’s filtering. After the extract’s volume was reduced to 40 ml in a water bath, it was combined in a separating funnel with 20 ml of diethyl ether. The separating funnel was placed on a stand to wait for the formation of an aqueous and diethyl layer after the mixture had been vigorously shaken. The aqueous portion was recovered, and the fraction containing diethyl ether was discarded. After adding 60 ml of n-butanol to the aqueous layer, vigorous shaking was used to thoroughly mix it in. The n-butanol extract was treated with a 10 ml solution of 5% NaCl. After the mixture was concentrated over a water bath, the cured saponins were baked to a dry consistency. Preparation of various concentrations of the extractsThe concentrations of the extracts were prepared by dissolving 100 mg of the oily residue with 1 ml of dimethyl sulfoxide to give a stock concentration of 100 mg/ml. After which, two-fold serial dilution was determined using the stock to obtain 50, 25, and 12.5 mg/ml concentrations. A 50 µl of the various concentrations were impregnated on perforated discs. These discs were dried and used to test for antibacterial activity. Antimicrobial susceptibility of extractsThe antimicrobial susceptibility of the extract was carried out using the disc diffusion method. The extract-impregnated discs containing the various concentrations were aseptically placed on the surfaces of the Mueller-Hinton agar plates which had been inoculated with isolates of S. aureus and P. aeruginosa isolates which had been standardized using the 0.5 McFarland. The plates were incubated at 37°C for 24 hours (CLSI, 2019). Determination of minimum inhibitory concentrationMinimum inhibitory concentrations (MICs) of the extracts on the isolates were determined as described by Ogbonna et al. (2013). The extracts were diluted ranging from 3.125 mg/ml to 12.25 mg/ml. One ml of the 0.5 McFarland standardized isolate was transferred into test tubes containing 2 ml of the various extract concentrations. The control contained only the extract without any bacterial isolates. Test tubes that were not turbid represented the MIC. Experiments were done in duplicates to corroborate the results. Determination of activity index of the plant extractsThe activity index was used to compare the inhibitory effect of the extract with that of the commercially available antibiotics. This was calculated as the mean zones of inhibition for the test extract divided by the mean inhibition zones for the commercial antibiotics (Naphtali et al., 2020). Ethical approvalNot needed for this study. ResultsThe identities of the bacterial isolates in response to morphological and biochemical tests are presented in Table 1. Results of the phytochemical composition of the plant extracts showed that the quantity of flavonoids in fresh ginger, fresh garlic, dry ginger, and dry garlic was 341.74 ± 1.16, 399.65 ± 0.63, 211.74 ± 1.16, and 206.11 ± 0.63 mg/100 g, respectively (Table 1). The amount of saponins present in fresh ginger, fresh garlic, dry ginger, and dry garlic was 3.10 ± 0.01, 12.77 ± 0.02, 2.5 ± 0.01, and 8.5 ± 0.02 mg/100 g (Table 2). Results of the antimicrobial activity of saponin extract of ginger on S. aureus showed that the zone inhibition of the extract on E1, E2, S1, S2, U1, U2, U3, W1, W2, and W3 at 100 mg/ml was 14 ± 5.6, 0, 11.0 ± 0.0, 9.0 ± 1.4, 13.0 ± 0.0, 18.0 ± 0.0, 0, 9.0 ± 1.4, 3.0 ± 0.0, and 13.0 ± 0.0 mm, respectively. The MIC of the extract on E1 was 25 mg/ml, the MIC of the extract on S1, S2, U1, U2, and W3 was 50 mg/ml while the MIC on W1 and W2 was 100 mg/ml (Table 3). The activity index ranged from 0.0 to 0.7. With the exception of isolates E2 and U3, all the isolates were susceptible to the extract at 100 mg/ml. The antimicrobial activity of the saponin extract of ginger on P. aeruginosa presented in Table 4 showed that the extract exhibited inhibitory activity on isolates SB2, WB6, and WB1 with zone inhibition of 11.5 ± 0.7, 4.0 ± 1.4, and 5.0 ± 0.0 mm, respectively. The MIC of the extract on isolate SB2 was 50 mg/ml while the MIC for the isolates WB6 and WB1 was 100 mg/ml. The antimicrobial activity of flavonoid extract of ginger on S. aureus presented in Table 5 showed that the zone inhibition of the extract at 100 mg/ml concentration on E1, E2, U2, U3, W1, W2, and W3 was 13.0 ± 1.4, 9.5 ± 0.7, 8.5 ± 0.7, 9.0 ± 1.4, 7.0 ± 2.8, 10.5 ± 0.7, and 13.0 ± 1.4 mm, respectively. The MIC of the extract on E1, E2, U2, U3, W1, and W2 was 50mg/ml, while the MIC on isolate W3 was 25 mg/ml. The activity index ranged from 0 to 0.9. The extract was more effective on E1 and W3, followed by W2. Results of the antimicrobial activity of the flavonoid extract of ginger on P. aeruginosa showed that the extract exhibited inhibitory activity on six out of the 10 isolates. The MIC on EB2, UP1, UP2, WB6, and WB1 was 100 mg/ml while the MIC on SB2 was 50 mg/ml. The activity index ranged from 0 to 0.5 (Table 6). The antimicrobial activity of the saponin extract of the garlic on S. aureus showed that the zone inhibition of the extract at 100 mg/ml concentration on E1, E2, U1, U2, U3, W1, and W2 was 12 ± 1.4, 9.5 ± 0.7, 8.0 ± 1.4, 8.5 ± 0.7, 8.0 ± 1.4, 10.5 ± 0.7, and 13 ± 0.0 mm, respectively (Table 7). The MIC of the afore-mentioned isolates was 50 mg/ml and the activity index ranged from 0 to 1.2. While the antimicrobial activity of the saponin extract of garlic on P. aeruginosa showed that the extract exhibited antimicrobial actions only on five isolates: EB1, EB2, SU2, UP2, and WB1. The zone diameter for these isolates at 100 mg/ml concentration was 5.5 ± 0.2, 7.0 ± 1.4, 12.0 ± 1.4, 8.5 ± 0.7, and 9.5 ± 0.7 (Table 8). The MIC of isolates EB1 was 50 mg/ml. The MIC of EB2 and WB1 was 100 mg/ml while the MIC of SU2 and UP2 was 25 mg/ml. The activity index ranged from 0 to 0.4. The antimicrobial activity of the flavonoid extract of the garlic on P. aeruginosa presented in Table 9 showed that the zone inhibition of the extract on EB1, EB2, SB1, SB2, SU1, SU2, UP1, UP2, WB6, and WB1 was 9.5 ± 0.7, 10.5 ± 0.7, 7.5 ± 0.7, 9.5 ± 0.7, 18.5 ± 0.7, 17.5 ± 0.7, 17.5 ± 0.7, 10.0 ± 0.0, 12.5 ± 0.7, and 12.0 ± 1.4 mm, respectively. The MIC of the extract on EB1, EB2, SB1, SB2, SU1, UP1, WB6, and WB1 was 50 mg/ml, the MIC for isolate SU2 was 25 mg/ml and the MIC for isolate UP2 was 100 mg/ml. The activity index ranged from 0.3 to 0.8. Results of the antimicrobial activity of the flavonoid extract of the garlic on S. aureus showed that the zone inhibition at 100 mg/ml concentration of the extract on E1, E2, S1, S2, U1, U2, U3, W1, W2, and W3 was 7.5 ± 0.7, 9.5 ± 0.7, 0, 0, 0, 19.5 ± 0.7, 0, 14.5 ± 0.7, 0, and 10.5 ± 0.7 mm. The MIC of the extract on isolates E1 and E2 was 50 mg/ml, the MIC of U2 and W1 was 25 mg/ml while the MIC of W3 was 100 mg/ml (Table 10). The activity index ranged from 0 to 0.6. More so, isolates U2 were more susceptible to the extract followed by W1 and W3 while S1, S2, U1, U3, and W2 were completely resistant to the extract. The minimum inhibitory concentrations and the plates showing the zone diameter of some of the bioactive components on the isolates are presented in Table 11 and Figure 1, respectively. Table 1. Morphological and biochemical characteristics of Pseudomonas and Staphylococcal Isolates.
Table 2. Phytochemical composition of plant extracts.
Table 3. Effect of the Saponin extract of Z. officinale on S. aureus.
Table 4. Effect of the Saponin extract of Z. officinale on P. aeruginosa.
DiscussionPhytochemicals are secondary metabolites present in plants. These phytochemicals could influence the antimicrobial activities of the plants (Naphtali et al., 2020). In the present study, the presence of flavonoids and saponins was detected in the various plant extracts. The quantities of the screened phytochemicals varied across the plant (spice) as well as the extraction solvent used. The present study showed that there was a significant difference (p ≤ 0.05) between the quantities of flavonoids and saponins present in the different plant extracts. The quantity of flavonoids in fresh garlic was significantly (p ≤ 0.05) higher than the flavonoid content of the fresh ginger, dry ginger, and dry garlic. The extract with the second highest flavonoid content was fresh ginger while dry garlic had the least flavonoid content. Similarly, the fresh saponin content in the fresh garlic extract was significantly (p ≤ 0.05) higher than the quantities of saponins obtained from fresh ginger, dry garlic, and dry ginger. Although dry garlic extract had the second largest quantity of saponins, it was not significantly different (p ˃ 0.05) from the quantities of saponins obtained from fresh ginger. Flavonoids and saponins have been reported as some of the secondary metabolites in ginger and garlic, thus, the present study agrees with previous research (Islam et al., 2014; Emmanuel et al., 2021; Ahmed et al., 2022). For instance, flavonoids are phenolic in nature and are cytoplasmic poisons that inhibit the activity of enzymes. Saponins are surface active agents that change the permeability of the cells, facilitating the flow of toxic materials or leakages of essential cell constituents (Trease and Evans, 2002). Table 5. Effect of the flavonoid extract of Z. officinale on S. aureus.
Table 6. Effect of the flavonoid extract of Z. officinale on P. aeruginosa.
Table 7. Effect of the Saponin extract of A. sativum on S. aureus.
Table 8. Effect of the Saponin extract of A. sativum P. aeruginosa.
Table 9. Effect of the Flavonoid extract of A. sativum on P. aeruginosa.
Table 10. Effect of the Flavonoid extract of A. sativum on S. aureus.
Table 11. Minimal inhibitory concentrations of the extracts on the bacterial isolates.
Fig. 1. Zone diameter of some bioactive components on the isolates. A: flavonoid of ginger on P. aeruginosa. B: Saponins of ginger on S. aureus. The flavonoids and saponins derived from garlic and ginger exhibited varying antibacterial activity on isolates of P. aeruginosa and S. aureus. The present study showed that the antibacterial activity of flavonoids derived from garlic and ginger was more effective against P. aeruginosa than the saponin from garlic and ginger. For the S. aureus isolate, the saponin of both garlic and ginger showed better antibacterial activity than the flavonoid components. Bioactive components such as saponins and flavonoids are compounds or secondary metabolites in plants that elicit pharmacological or toxicological effects in human and animals (Alamgir, 2018). The antibacterial activities of flavonoids and saponins are well documented. The high antibacterial activity of flavonoids over saponins could be attributed to their broad spectrum of activities. There is evidence that flavonoids have a wide range of chemical and biological properties, including antioxidizing and free radical scavenging properties, antibacterial, antiviral, anticancer, anti-inflammatory, and anti-allergic properties, as well as potential therapeutic agents against a wide range of diseases (Ross and Kasum, 2002; Williams et al., 2004; Cushnie and Lamb, 2005). In a previous study conducted in Kenya, rutin which is a flavonoid demonstrated very high antibacterial activity on both Gram-positive and Gram-negative isolates with the MIC on S. aureus around 10 µg/ml. They also reported that the antibacterial activity of the flavonoid compound at 200 µg/ml was comparable to the antibacterial effect of ciprofloxacin (Sintayehu et al., 2012). The in-vitro antimicrobial activity of the flavonoids extracted from Libyan algae showed a very high zone of inhibitions (14–20.5 mm) on S. aureus isolates (Alghazeer et al., 2017). The present study does not agree with Mandalari et al. (2007) who reported higher antibacterial activity of flavonoid extracts towards Gram-positive bacteria than Gram-negative bacteria (Mandalari et al., 2007). The differences between our studies could be attributed to the fact that we considered Pseudomonas in our study which was not in their study. Like flavonoids, the cytotoxicity of saponins has been reported in previous studies with effects extending to insecticidal, anticancer, and antioxidant activities (Muhammad et al., 2014). ConclusionBioactive components of plants have gained special interest since they have been reported to possess antimicrobial activities among other interesting benefits. The extract of flavonoids and saponins from ginger and garlic in the present study showed that they inhibited the growth of clinical isolates of P. aeruginosa and S. aureus. Although a high level of resistance was recorded by these isolates, especially against saponins, the effect of the extracts was based on the concentrations. Thus, high concentrations exhibited better antibacterial activity. Additionally, the flavonoid extract of ginger and garlic displayed better antibacterial activity on P. aeruginosa while the saponin extract of these spices was best on S. aureus. Fresh ginger and garlic have higher flavonoids and saponins than dried ginger and garlic suggesting that these plants could be used in treating infections from Staphylococcus aureus and P. aeruginosa. More research on the other bioactive components of these spices is recommended. AcknowledgmentsThe authors want to use this opportunity to acknowledge the laboratory technicians for their support in ensuring that the research was achieved. The authors also want to appreciate Mr. Cyprian Chioma for his efforts. Conflict of interestThe authors declare no conflict of interest. FundingThe study was self-funded. The authors declare that no external funding source was obtained in the course of the research. Authors’ contributionsAll authors participated in the design of the research, search for relevant literatures and execution of the laboratory protocols. Data availabilityThe data should be readily available for use. ReferencesAhmed, N., Karobari, M.I., Yousaf, A., Mohamed, R.N., Arshad, S., Basheer, S.N., Peeran, S.W., Noorani, T.Y., Assiry, A.A., Alharbi, A.S. and Yean, C.Y. 2022. The antimicrobial efficacy against selective oral microbes, antioxidant activity and preliminary phytochemical screening of Zingiber officinale. Infect. Drug. Resist. 15(May), 2773–2785. Akani, N.P. and Barika P.N. 2018. Antibacterial activity of bryophyte (Funaria hygrometrica) on some throat Isolates. Int. J. Health. Pharm. Res. 4(1), 1–8. Alamgir, A.N.M. 2018. Therapeutic use of medicinal plants and their extracts: volume 2: phytochemistry and bioactive compounds, 1st ed. Cham, Switzerland: Springer International Publishing; doi: 10.1007/978-3-319-92387-1. Alghazeer, R., Elmansori, A., Sidati, M., Gammoudi, F., Azwai, S., Naas, H., Garbaj, A. and Eldaghayes, I. 2017. Antibacterial activity of flavonoid extracts of two selected Libyan Algae against multi-drug-resistant bacteria isolated from food products. J. Bios. Med. 05(01), 26–48. Arora, S. and Itankar, P. 2018. Extraction, isolation and identification of flavonoid from Chenopodium album aerial parts. J.Trad. and Compl. Med. 8(4):476–482. Chavunduka, E.L. 2017. Christianity, African Religion and African Medicine in World Council of Churches. 1990. Available via http://wcc.coe.org/wcc/what/interreligions/cd33-02.htm Clinical and Laboratory Standard Institute (CLSI). 2019. 28th ed. Performance standard for antimicrobial disk susceptibility tests.Wayne: Clinical and Laboratory Standard Institute, . Cushnie, T.P.T. and Lamb, A.J. 2005. Antimicrobial activity of flavonoids. Int. J. Antim. Agt. 26, 343–356 Emmanuel, R. Ehinmitan, B. and Joseph. 2021. Antimicrobial activity of Zingiber officinale and Allium Sativum on some drug-resistant bacterial isolates. J. Appl. Sci. Environ. Manage. 25(6), 1053–1058. Gul, R., Jan, S.U., Faridullah, S., Sherani, S. and Jahan, N. 2017. Preliminary phytochemical screening, quantitative analysis of alkaloids, and antioxidant activity of crude plant extracts from ephedra intermedia indigenous to balochistan. The Sci. World J. 2017, 1–7. Husain, F.M., Ahmad, I., Khan, M.S., Ahmad, E., Tahseen, Q., Khan, M.S. and Alshabib, N.A. 2015. Sub-MICs of Mentha piperita essential oil and menthol inhibits AHL mediated quorum sensing and biofilm of gram-negative bacteria. Front. Microbiol. 6, 420. Islam, K., Rowsni, A.A., Khan, M. and Kabir, S. 2014. Antimicrobal activity of ginger (Zingiber Officinale) extracts against food-borne pathogenic bacteria. Int. J. of Sci. Env. Tech. 3(3), 867–871. Kali, A., Bhuvaneshwar, D., Charles, P.M.V. and Seetha, K.S. 2016. Antibacterial synergy of curcumin with antibiotics against biofilm producing clinical bacterial isolates. J. basic Clin. Pharm. 7(3), 93–96. Khalid, S., Shahzad, A., Basharat, N., Abubakar, M. and Anwar, P. 2018. Phytochemical screening and analysis of selected medicinal plants in phytochemistry and biochemistry. J. Phytoch. Bioch. 2(1), 2–4. Kibiti, C.M. and Afolayan, A.J. 2015. Preliminary phytochemical screening and biological activities of bulbine abyssinica used in the folk medicine in the Eastern Cape Province, South Africa. Evid. Compl. Alt. Med. 2015, 617607. Malari, G., Bennett, R.N., Bisignano, G., Trombetta, D., Saija, A., Faulds, C.B., Gasson, M.J. and Narbad, A. 2007 Antimicrobial activity of flavonoids extracted from bergamot (Citrus bergamia Risso) peel. A byproduct of the essential oil industry. J. App. Microbiol. 103, 2056–2064. Magryś, A., Olender, A. and Tchórzewska, D. 2021. Antibacterial properties of Allium sativum L. against the most emerging multidrug-resistant bacteria and its synergy with antibiotics. Arch. Microbiol. 203(5), 2257–2268. Mahomoodally, M.F. 2013. Traditional medicine in Africa: an appraisal of ten potent African medicinal plants. Evid. Compl. Alt. Med. 2013, 14. Mostafa, A.A., Al-Askar, A.A., Almaary, K.S., Dawoud, T.M., Sholkamy, E.N. and Bakri, M.M. 2018. Antimicrobial activity of some plant extracts against bacterial strains causing food poisoning diseases. Saudi J. Biol. Sci. 25(2),361–366. Muhammad, S., Shah, M., Sadiq, A., Muhammad, S., Shah, H. and Khan, S. 2014. Extraction of saponins and toxicological profile of Teucrium stocksianum boiss extracts collected from District Swat, Pakistan. Biol. Res. 47, 1–5. Naphtali, E., Tahir, F. and Agbo, E.B. 2020. Evaluation of phytochemicals and activity index of some plant leaf extracts on typhoidal and non-typhoidal Salmonella isolates from selected hospitals in Bauchi, Nigeria. GSC Biol. Pharm. Sci. 10(02), 120–129 Ogbonna, C.N., Nozaki, K. and Yajima, H. 2013. Antimicrobial activity of Xylopia aethiopica, Aframomum melegueta and Piper guineense ethanolic extracts and the potential of using Xylopia aethiopica to preserve aqueous orange juice. Afr. J. Biotech. 12(16), 1993–1998. Rahman, M.A., Shaha, S.K., Haque, S.D., Zahan, R., Alam, T., Mandal, S.K. and Mamun, M.S.H. 2020. Antibacterial effect of Ginger (Zingiber officinale) against Staphylococcus aureus. Mediscope 7(1), 31–37. Romero, C.M., Vivacqua, C.G., Abdulhamid, M.B., Baigori, M.D., Slanis, A.C., Allori, M.C.G. and Tereschuk, M.L. 2016. Biofilm inhibition activity of traditional medicinal plants from northwestern Argentina against native pathogen and environmental microorganisms. Revista da Sociedade Bras. de Med. Trop. 49(6), 703–712. Ross, J. and Kasum, C. 2002. Dietary flavonoids: bioavailability, metabolic effects and safety. Ann. Rev. Nut. 22, 19–34. Shah, S.M., Sadiq, A., Shah, S.M. and Khan, S. 2014. Extraction of saponins and toxicological profile of Teucrium stocksianum boiss extracts collected from District Swat, Pakistan. Biol. Rese. 47(1), 65. Sintayehu, B., Asres, K., Mazumder, A. and Bucar, F. 2012. Isolation of an antibacterial flavonoid glycoside from the leaves of Cineraria abyssinica. Ethi. Pharm. J. 28(2), 87–94. Trease, G. and Evans, W. 2002. Phytochemicals. In Pharmacognosy, 15th ed. London, UK: Saunders Publishers, pp: 42–393. Williams, R.J., Spencer, J.P. and Rice Evans, C. 2004. Flavonoids: antioxidants or signaling molecules. Free Rad. Biol. Med. 36, 838–849. Yin, H., Deng, Y., Wang, H., Liu, W., Zhuang, X. and Chu, W. 2015. Tea polyphenols as an antivirulence compound disrupt quorum-sensing regulated pathogenicity of Pseudomonas aeruginosa. Sci. Rep. 5(1), 16158. | ||
| How to Cite this Article |
| Pubmed Style Robinson VK, Barika PN, Ogbonna SI, Nengi-benwari A. Antimicrobial properties of flavonoids and saponins of ginger (Zingiber officinale L) and garlic (Allium sativum) on Staphylococcus aureus and Pseudomonas aeruginosa. J Microbiol Infect Dis. 2024; 14(3): 120-130. doi:10.5455/JMID.2024.v14.i3.5 Web Style Robinson VK, Barika PN, Ogbonna SI, Nengi-benwari A. Antimicrobial properties of flavonoids and saponins of ginger (Zingiber officinale L) and garlic (Allium sativum) on Staphylococcus aureus and Pseudomonas aeruginosa. https://www.jmidonline.org/?mno=215584 [Access: January 25, 2026]. doi:10.5455/JMID.2024.v14.i3.5 AMA (American Medical Association) Style Robinson VK, Barika PN, Ogbonna SI, Nengi-benwari A. Antimicrobial properties of flavonoids and saponins of ginger (Zingiber officinale L) and garlic (Allium sativum) on Staphylococcus aureus and Pseudomonas aeruginosa. J Microbiol Infect Dis. 2024; 14(3): 120-130. doi:10.5455/JMID.2024.v14.i3.5 Vancouver/ICMJE Style Robinson VK, Barika PN, Ogbonna SI, Nengi-benwari A. Antimicrobial properties of flavonoids and saponins of ginger (Zingiber officinale L) and garlic (Allium sativum) on Staphylococcus aureus and Pseudomonas aeruginosa. J Microbiol Infect Dis. (2024), [cited January 25, 2026]; 14(3): 120-130. doi:10.5455/JMID.2024.v14.i3.5 Harvard Style Robinson, V. K., Barika, . P. N., Ogbonna, . S. I. & Nengi-benwari, . A. (2024) Antimicrobial properties of flavonoids and saponins of ginger (Zingiber officinale L) and garlic (Allium sativum) on Staphylococcus aureus and Pseudomonas aeruginosa. J Microbiol Infect Dis, 14 (3), 120-130. doi:10.5455/JMID.2024.v14.i3.5 Turabian Style Robinson, Victor Kasi, Prince Nornubari Barika, Solomon Ikechi Ogbonna, and Anita Nengi-benwari. 2024. Antimicrobial properties of flavonoids and saponins of ginger (Zingiber officinale L) and garlic (Allium sativum) on Staphylococcus aureus and Pseudomonas aeruginosa. Journal of Microbiology and Infectious Diseases, 14 (3), 120-130. doi:10.5455/JMID.2024.v14.i3.5 Chicago Style Robinson, Victor Kasi, Prince Nornubari Barika, Solomon Ikechi Ogbonna, and Anita Nengi-benwari. "Antimicrobial properties of flavonoids and saponins of ginger (Zingiber officinale L) and garlic (Allium sativum) on Staphylococcus aureus and Pseudomonas aeruginosa." Journal of Microbiology and Infectious Diseases 14 (2024), 120-130. doi:10.5455/JMID.2024.v14.i3.5 MLA (The Modern Language Association) Style Robinson, Victor Kasi, Prince Nornubari Barika, Solomon Ikechi Ogbonna, and Anita Nengi-benwari. "Antimicrobial properties of flavonoids and saponins of ginger (Zingiber officinale L) and garlic (Allium sativum) on Staphylococcus aureus and Pseudomonas aeruginosa." Journal of Microbiology and Infectious Diseases 14.3 (2024), 120-130. Print. doi:10.5455/JMID.2024.v14.i3.5 APA (American Psychological Association) Style Robinson, V. K., Barika, . P. N., Ogbonna, . S. I. & Nengi-benwari, . A. (2024) Antimicrobial properties of flavonoids and saponins of ginger (Zingiber officinale L) and garlic (Allium sativum) on Staphylococcus aureus and Pseudomonas aeruginosa. Journal of Microbiology and Infectious Diseases, 14 (3), 120-130. doi:10.5455/JMID.2024.v14.i3.5 |